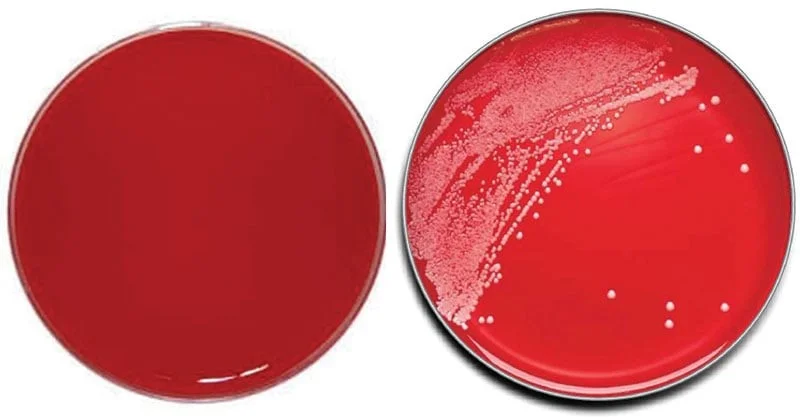
محیط کشت هارت اینفیوژن آگار

فهرست مطالب
نمایش
مقدمهای بر محیط کشت محیط کشت هارت اینفیوژن آگار
- ارگانیسمهای سختپسند (Fastidious) که نیازهای غذایی خاصی دارند را میتوان در محیطهای اینفیوژن کشت کرد.
- میت اینفیوژن ها (Meat infusions) جزو نخستین محیطها برای کشت باکتریها بوده است.
- Huntoon با استفاده از قلب تازه گاو و پپتون (Peptone) محیطی تهیه کرد که به نام هارت اینفیوژن آگار معروف شد.
- او نشان داد که میتوان از این محیط برای تقویت رشد میکروارگانیسمهای سختپسند از نظر مواد غذایی، بدون افزودن موادی جهت غنیسازی آن (مانند خون حیوانات)، استفاده کرد.
- محیط کشت هارت اینفیوژن آگار یک محیط رشد همه منظوره است. این محیط برای کشت میکروارگانیسمهای سختپسند و به عنوان یک محیط پایه با کاربردهای متنوع توصیه میشود.
ترکیبات محیط کشت هارت اینفیوژن آگار
| اجزاء ترکیب | گرم در لیتر |
| قلب گاو، فرم اینفیوژن | 500 |
| کلرید سدیم | 5 |
| تریپتوز (Tryptose) | 10 |
| آگار | 15 |
| آب دمین (Demin) | 1000 |
pH نهایی (در دمای 25 درجه سانتیگراد): 0.2 ± 7.4
اصول هارت اینفیوژن آگار
- تریپتوز و اینفیوژن قلب گاو نیازهای غذایی باکتریهای بیماریزا را فراهم میکنند.
- اینفیوژن قلب گاو ترکیبات نیتروژندار و اسیدهای آمینه لازم برای رشد باکتریهای سختپسند را تامین میکند.
- کلرید سدیم الکترولیتهای ضروری را فراهم و تعادل اسمزی را حفظ میکند.
- آگار نیز عامل انجماد است.
آمادهسازی و روش استفاده از محیط کشت هارت اینفیوژن آگار
- 40 گرم را در 1000 میلیلیتر آب مقطر بریزید.
- حرارت داده تا به جوش آید و محیط کاملا حل شود.
- محیط را با اتوکلاو کردن با فشار 15 پوند (121 درجه سانتیگراد) به مدت 15 دقیقه، استریل کنید.
- در صورت تمایل میتوان 5 درصد v/v (درصد حجمی – حجمی) خون دفیبرینشده استریل اضافه کرد.
- محیط را خوب مخلوط کنید و در ظروف آزمایشگاهی بریزید.
- نمونه را در اسرع وقت پس از دریافت در آزمایشگاه، به صورت رگهای تلقیح کنید.
- اگر مستقیماً با سواب عمل کشت انجام میشود، سواب را روی ناحیه کوچکی از سطح آگار بغلتانید و برای ایزوله کردن آرگانیسم آن را به صورت رگهای کشت دهید.
- محیط را به صورت هوازی یا در شرایط 5 تا 10 درصد CO2 در دمای 33 تا 37 درجه سانتیگراد به مدت 18 تا 24 ساعت انکوبه کنید.
- مورفولوژی معمولی کلنی را بررسی کنید.
تفسیر نتایج محیط کشت هارت اینفیوژن آگار
| ارگانیسم | رشد |
| اشریشیا کلی (Escherichia coli) | رشد زیاد؛ بتا همولیز (Beta hemolysis) |
| استافیلوکوکوس اورئوس (Staphylococcus aureus) | رشد خوب و زیاد؛ بتا همولیز |
| نایسریا مننژیتید (Neisseria meningitides) | رشد زیاد؛ بدون همولیز |
| استرپتوکوک پنومونیه (Streptococcus pneumoniae ) | رشد خوب؛ آلفا همولیز (Alpha hemolysis) |
| استرپتوکوک پیوژنز (Streptococcus pyogenes) | رشد خوب؛ آلفا همولیز ؛ بتا همولیز |
موارد استفاده از محیط کشت هارت اینفیوژن آگار
- استفاده از این آگار در روشهای کیفی برای جداسازی طیف گستردهای از میکروارگانیسمهای سختپسند توصیه میشود.
- همچنین میتوان از آن برای کشت گونههای ویبریو (Vibrio) و استرپتوکوک (Streptococci) استفاده کرد.
- برای کشت انبوه باکتریهای مورد نیاز در تهیه واکسن، از این محیط استفاده میشود.
- در مورد مکمل خون، میتوان از محیط کشت هارت اینفیوژن آگار جهت مطالعه واکنشهای همولیتیک استفاده کرد.
- همچنین میتوان آن را با مکملهایی نظیر گلوکز، سرم اسب و آنتیبیوتیکها برای کشت انواع مختلف ارگانیسمها، تکمیل کرد.
- از این محیط برای جداسازی و شمارش استرپتوکوکهای همولیتیک در شیر استفاده میشود.
- عمق آگار را میتوان به عنوان یک گرادیان اکسیژن برای تعیین میزان نیاز به اکسیژن تلقیح با مشاهده محل رشد در لوله آزمایش، استفاده کرد.
محدودیتها
- برای شناسایی کامل توصیه میشود آزمایشات بیوشیمیایی، ایمونولوژیک، مولکولی یا طیفسنجی جرمی روی کلنیهای حاصل از کشت خالص انجام شود.
- با توجه به نیازهای غذایی مختلف برخی از ارگانیسمها، ممکن است گاهی با ایزولههایی مواجه شویم که در این محیط رشد نمیکنند یا رشد ضعیفی دارند.
جهت خرید و یا استعلام قیمت با ما تماس بگیرید یا در واتسپ پیام بزارید
مطالب مرتبط:
- هکتون انتریک آگار (محیط کشت HE): ترکیب، اصول، آمادهسازی و نتایج
- محیط کشت CVA (کمپیلوباکتر بلاد آگار): ترکیب، اصول، آمادهسازی، نتایج و کاربرد
- زاپکس آگار (محیط کشت CZA): ترکیب، اصول، آمادهسازی، نتایج و کاربرد
- محیط کشت BSA: ترکیب، اصول، آمادهسازی، نتایج و کاربرد
- محیط کشت DCA: ترکیب، اصول، روش آمادهسازی، نتایج و کاربرد
مترجم: صادق حسینیکیا